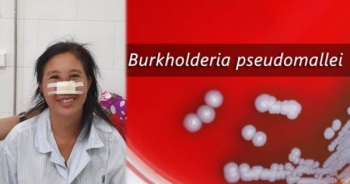
Bệnh nhân Whitmore tổn thương mũi đã được xuất viện

Bệnh nhân Whitmore tổn thương mũi đã được xuất viện
Thông tin từ Bệnh viện Bạch Mai, sau hơn 3 tuần điều trị tích cực với sự phối hợp hiệu quả của nhiều chuyên khoa trong Bệnh viện Bạch Mai, bệnh nhân bị vi khuẩn Whitmore gây tổn thương áp-xe mũi đã ổn định và được xuất viện vào ngày 19/9/2019.